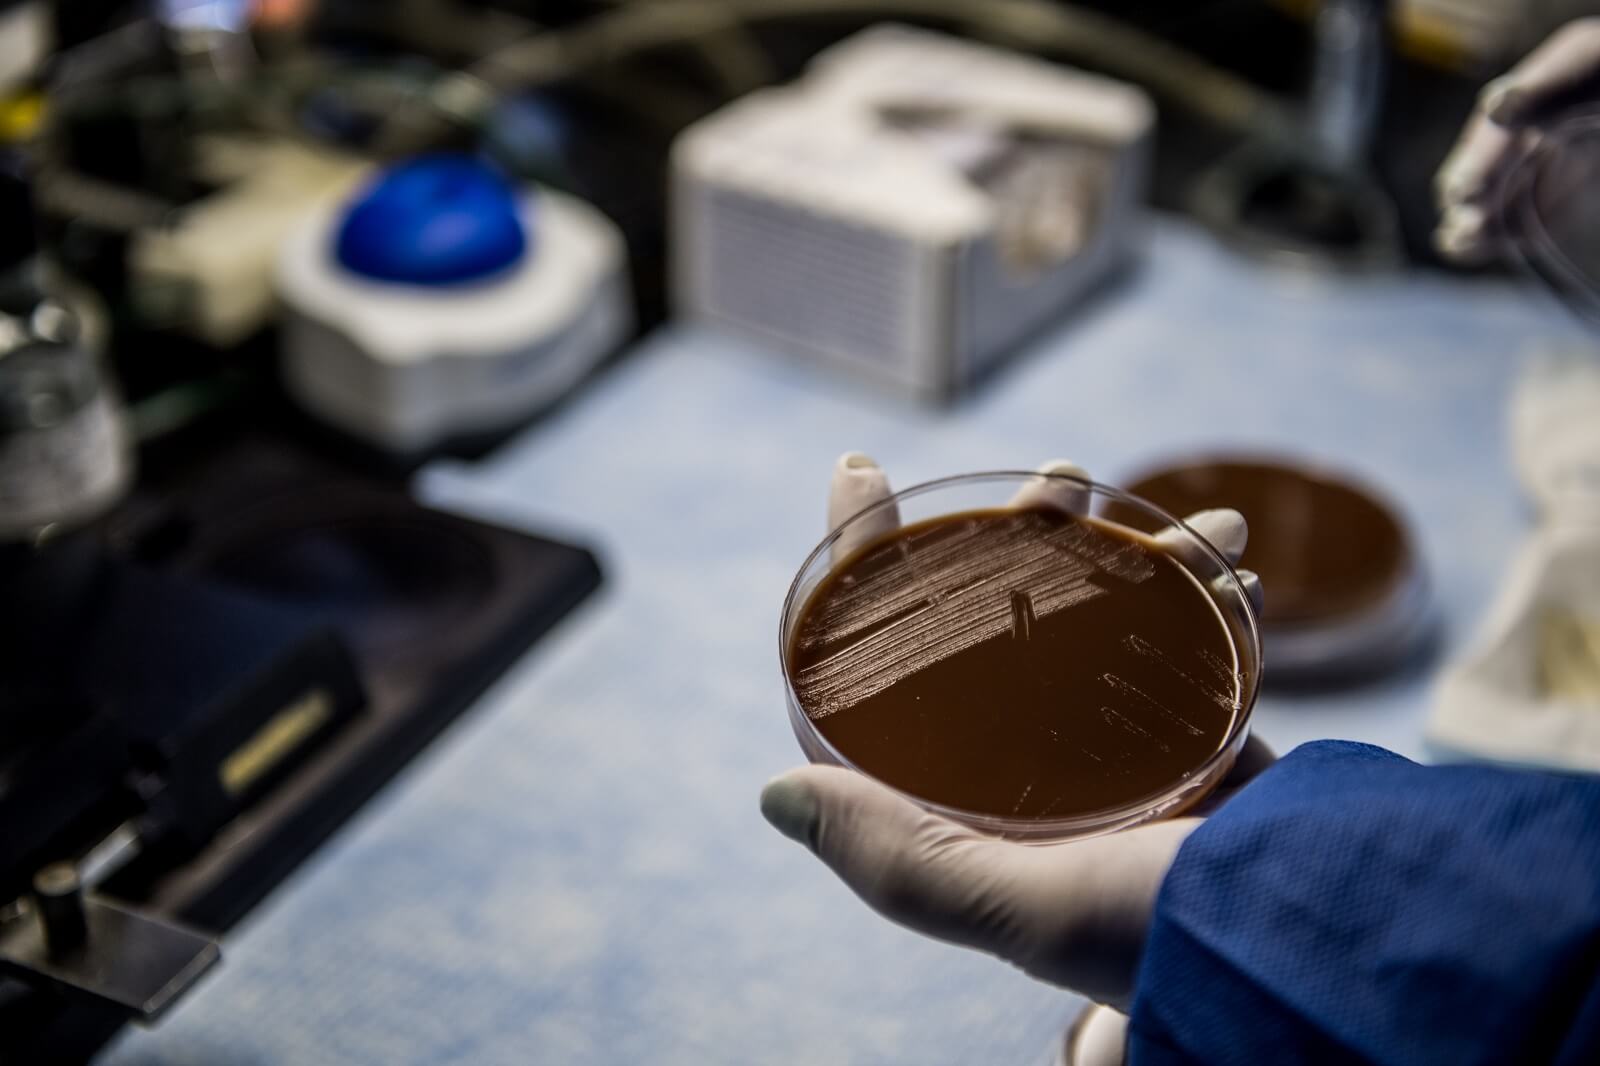
Gardp Gonorrhoea Phase 3 Trial Alabama 1.jpg
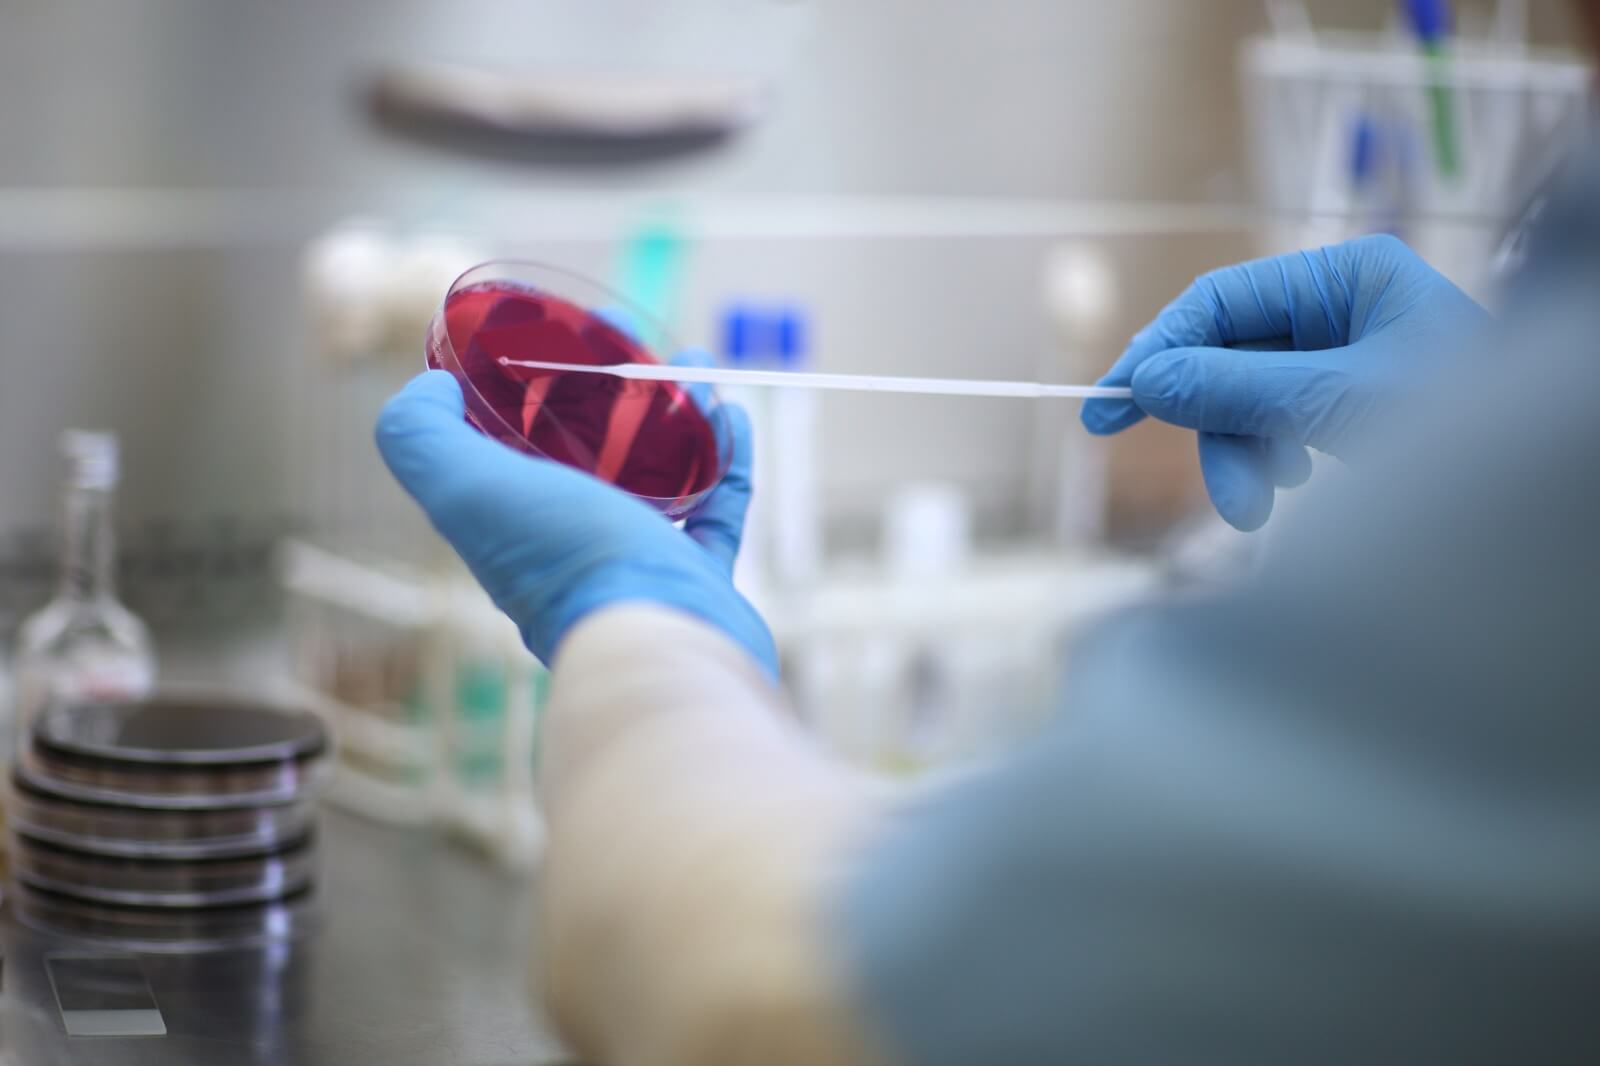
Bacteria Culture Close Up 2 Gardp.jpg

Wellcome Trust funds GARDP’s efforts to develop and deliver antibiotics for drug-resistant infections

GENEVA – The Global Antibiotic Research and Development Partnership (GARDP) is pleased to announce £1 million investment from the Wellcome Trust. This funding will contribute … Wellcome Trust funds GARDP’s efforts to develop and deliver antibiotics for drug-resistant infections